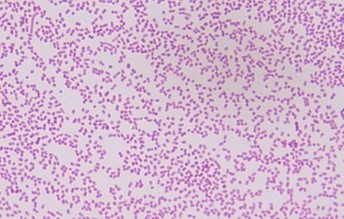

Pasteurella pertenece a la familia Pasteurellaceae. Son bacterias Gram negativo, anaerobias facultativas, inmóviles, no esporuladas y con forma de cocobacilo pleomórfico, pudiéndose observar formas cocoides y bacilos cortos o filamentosos, que se pueden encontrar aislados, agrupados en parejas o formando cadenas cortas.
P. multocida crece bien en medios de agar sangre, agar chocolate y Mueller-Hinton. Tras 24 horas de incubación en agar sangre, forma colonias lisas de 1-2 milímetros de diámetro, de un color gris azulado brillante, no hemolíticas y en ocasiones mucosas. P. multocida se divide en tres subespecies (multocida, septica y gallicida) y en cinco serotipos en función del antígeno capsular (A, B, D, E o F).
El género Pasteurella comprende actualmente 20 especies que son normalmente patógenas para los animales y que, a veces, causan infecciones en el hombre (9).
Viabilidad, propagación y transmisión
Reservorio
La flora habitual de las vías respiratorias y gastrointestinales de mamíferos (sobre todo perros y gatos) y aves.
Hospedadores
Humanos, mamíferos (felinos, cánidos, caprinos, ovinos, roedores, bovinos, cérvidos, equinos, lepóridos, porcinos) y aves.
Dosis Infectiva Mínima (DIM)
Se desconoce en la actualidad.
Supervivencia ambiental
En el ambiente exterior sobrevive días en agua destilada y salada (14 días a 4 °C, menos de 24 horas a 37 °C), en purines de cerdo (3 días a 4 °C y 6 días a 37 °C), semanas en el suelo húmedo y más de 2 meses en las carcasas o cadáveres de animales enterrados (4). También sobrevive en sangre (8).
Es sensible a la desecación y al frío (4).
Formas de resistencia
No presenta formas de resistencia.
Mecanismo de propagación y transmisión
La transmisión al hombre se produce principalmente por inoculación directa, a través de arañazos o mordeduras de animales (zoonosis), sobre todo de gatos y de perros y, con menor frecuencia, por contaminación de heridas o lesiones previas en la piel por contacto con secreciones o saliva de animales, normalmente por el lamido de los animales y, excepcionalmente, por pinchazos o cortes con plantas o herramientas contaminadas (fómites) (4).
También puede darse la transmisión por contacto de la mucosa nasofaríngea con gotitas, secreciones respiratorias o saliva de animales (3) (4) (7) (8).
La mayor transmisión se produce en colectivos o personas en contacto con animales, sobre todo en personas con patologías subyacentes, ancianos e inmunodeprimidos.
Ocasionalmente, algunos pacientes sin antecedentes de exposición o contacto con animales desarrollan infecciones por esta bacteria. En 1980 se describió un brote de infección nosocomial por P. multocida, pero no fue posible determinar su origen ni el mecanismo de transmisión.
La transmisión de persona a persona es poco frecuente, aunque puede darse por contacto con individuos colonizados y por transfusión de sangre contaminada (2). También se sospecha, pero no está confirmada, la transmisión por ingesta de agua o alimentos contaminados (4) (9).
Las cucarachas y otros vectores pueden facilitar la dispersión mediante la contaminación de alimentos (8).
Vías de entrada
Percutánea. Mucosas.
Distribución geográfica
Mundial.
Efectos sobre la salud
Grupo de riesgo
2
(Ver Anexo II RD 664/1997 )Infección
Pasteurelosis: es una infección poco frecuente en humanos. Se suele producir por la mordedura o el arañazo de un animal y afecta a la piel y a los tejidos blandos de la zona de la herida. Se caracteriza por un periodo de incubación inferior a 24 horas, normalmente de 3-6 horas y síntomas como: dolor intenso, inflamación, rápido desarrollo de celulitis, con o sin formación de abscesos y secreción purulenta o serosanguinolenta, puede aparecer fiebre. También se han descrito especialmente en adultos con patologías subyacentes, infecciones de vías respiratorias superiores (epiglotitis, sinusitis, otitis y amigdalitis) e inferiores (neumonía, bronquitis, abscesos pulmonares, empiema), artritis, osteomielitis, infecciones genitourinarias y puerperales, endoftalmitis, peritonitis, apendicitis, endocarditis y meningitis. Las infecciones sistémicas e invasivas graves (sepsis y bacteriemia) suelen darse en pacientes adultos con distintos y variados factores de comorbilidad (1) (9).
Efectos alérgicos (Ver Anexo II RD 664/1997 ) / (Ver Allergen )
No se han descrito
Efectos tóxicos (Ver Anexo II RD 664/1997 )
No se han descrito
Efectos cancerígenos (Ver International Agency for Research On Cancer - IARC )
No se han descrito
Efectos en la maternidad
En la mujer embarazada se puede dar la sepsis puerperal (1).
Aunque es raro, se puede producir la transmisión vertical a través de la infección transplacentaria, endometritis y colonización del tracto genital (2) (7) (8).
La septicemia durante el embarazo ha dado lugar a aborto séptico, meningitis neonatal, infección intrauterina y muerte fetal (1) (2). En casi todos los casos de meningitis neonatal (por lo general con septicemia) se atribuyó a la exposición directa a mascotas u otros animales domésticos (3).
Enfermedad
| CIE-10 | Nombre | Enfermedad de Declaración Obligatoria |
|---|---|---|
| A28.0 | Pasteurelosis | No |
Actividades laborales con riesgo
Clasificación Nacional de Actividades Económicas (CNAE)
| CNAE 2009 | Descripción |
|---|---|
| A0141 | Explotación de ganado bovino para la producción de leche |
| A0142 | Explotación de otro ganado bovino y búfalos |
| A0143 | Explotación de caballos y otros equinos |
| A0145 | Explotación de ganado ovino y caprino |
| A0146 | Explotación de ganado porcino |
| A0147 | Avicultura |
| A0148 | Otras explotaciones de ganado |
| A0162 | Actividades de apoyo a la ganadería |
| A0170 | Caza, captura de animales y servicios relacionados |
| C1011 | Procesado y conservación de carne, excepto volatería |
| C1012 | Procesado y conservación de volatería |
| C1013 | Elaboración de productos cárnicos y de volatería |
| C1424 | Confección de prendas de vestir de cuero y peletería |
| C1511 | Preparación, curtido y teñido de cueros y pieles |
| F4341 | Construcción de cubiertas |
| G4611 | Actividades de intermediarios del comercio al por mayor de materias primas agrarias, animales vivos, materias primas textiles y productos semielaborados |
| G4623 | Comercio al por mayor de animales vivos |
| G4632 | Comercio al por mayor de carne, productos cárnicos; pescado y productos del pescado |
| G4722 | Comercio al por menor de carne y productos cárnicos |
| G4776 | Comercio al por menor de flores, plantas, fertilizantes, animales de compañía y alimentos para estos |
| H4941 | Transporte de mercancías por carretera |
| N7500 | Actividades veterinarias |
| O8130 | Actividades de jardinería |
| S9141 | Actividades de los jardines botánicos y los parques zoológicos |
Clasificación Nacional de Ocupaciones (CNO)
| CNO 2011 | Descripción |
|---|---|
| 2130 | Veterinarios |
| 2210 | Profesores de universidades y otra enseñanza superior (excepto formación profesional) |
| 2421 | Biólogos, botánicos, zoólogos y afines |
| 3142 | Técnicos agropecuarios |
| 3327 | Ayudantes de veterinaria |
| 5893 | Cuidadores de animales y adiestradores |
| 5993 | Agentes forestales y medioambientales |
| 6120 | Trabajadores cualificados en huertas, invernaderos, viveros y jardines |
| 6201 | Trabajadores cualificados en actividades ganaderas de vacuno |
| 6202 | Trabajadores cualificados en actividades ganaderas de ovino y caprino |
| 6203 | Trabajadores cualificados en actividades ganaderas de porcino |
| 6205 | Trabajadores cualificados en la avicultura y la cunicultura |
| 6209 | Trabajadores cualificados en actividades ganaderas no clasificados bajo otros epígrafes |
| 6430 | Trabajadores cualificados en actividades cinegéticas |
| 7291 | Montadores de cubiertas |
| 7533 | Instaladores y reparadores en tecnologías de la información y las comunicaciones |
| 7701 | Matarifes y trabajadores de las industrias cárnicas |
| 7836 | Curtidores y preparadores de pieles |
| 8155 | Operadores de máquinas para tratar pieles y cuero |
| 8160 | Operadores de máquinas para elaborar productos alimenticios, bebidas y tabaco |
| 9512 | Peones agrícolas en huertas, invernaderos, viveros y jardines |
| 9520 | Peones ganaderos |
| 9530 | Peones agropecuarios |
| 9700 | Peones de las industrias manufactureras |
Prevención y control
Desinfectantes
Hipoclorito de sodio al 1 %, compuestos fenólicos, etanol al 70 %, glutaraldehído, yodóforos y ácido peracético (8).
Inactivación física
Inactivación por calor húmedo a 121 ºC durante 20 minutos, calor seco a 165-170 ºC durante 2 horas, microondas, luz UV, radiación gamma y desecación (4) (8).
Antimicrobianos
Penicilina, tetraciclinas, cefalosporinas de segunda y tercera generación, quinolonas fluoradas, cotrimoxazol, macrólidos, aminoglucósidos y fosfomicina (1). Como profilaxis frente a las mordeduras de animales, la combinación de amoxicilina-ácido clavulánico o doxiciclina-metronidazol o levofloxacina (4).
Pueden darse resistencias a los distintos antibióticos.
Vacunación
No disponible
Medidas preventivas generales
Control veterinario de los animales domésticos y de compañía y evitar el contacto con animales salvajes.
Evitar situaciones estresantes en la cría, manipulación y transporte de los animales para evitar arañazos o mordeduras. Evitar lametazos en heridas.
Mantener los locales de trabajo, de cría y estabulación de los animales, y los equipos y herramientas de trabajo en condiciones adecuadas de ventilación, limpieza y desinfección.
Evitar o reducir el uso de herramientas cortantes o punzantes; en caso necesario, utilizarlas con las debidas protecciones y precauciones.
Adecuadas medidas de higiene: lavado de manos con agua y jabón al finalizar la jornada laboral, después de quitarse los guantes y tras el contacto con elementos o animales contaminados. Limpieza y desinfección de los cortes, arañazos o heridas en la piel y cubrirlas con apósitos estériles e impermeables. Utilizar ropa de trabajo y equipos de protección individual de cierta resistencia mecánica.
Control de vectores, desinsectación y desratización.
Precauciones en centros sanitarios
En hospitales, centros sanitarios y veterinarios, adoptar las Precauciones Estándar.
EPI
Protección de las manos: guantes de protección frente a microorganismos en caso de contacto o manipulación de animales o materiales potencialmente infecciosos. Guantes de resistencia mecánica en caso de riesgo de arañazos, mordeduras, cortes o abrasiones. Los guantes deben solapar completamente con las mangas de la ropa de trabajo.
Protección respiratoria: mascarillas autofiltrantes tipo FFP2, preferiblemente FFP3 para operaciones en las que se genere gran cantidad de bioaerosoles.
Protección ocular o facial: gafa de protección de montura universal en caso de riesgo de contacto accidental o lesión en el ojo, o pantalla de protección facial (símbolo de marcado en montura 3) en caso de riesgo de exposición a salpicaduras.
Seguridad en laboratorio
Nivel de contención: 2
El principal riesgo es la inoculación accidental a través de mordeduras arañazos o lametazos de animales infectados, la contaminación de heridas y la exposición a salpicaduras o aerosoles.
Los especímenes o muestras más peligrosas son: los animales, sus secreciones respiratorias y la sangre (4) (8).
Se requieren las prácticas y la contención de un nivel 2 de bioseguridad para realizar cultivos o para manipular muestras o animales infectados. Utilizar cabina de seguridad biológica, cuando se puedan producir bioaerosoles, salpicaduras o se trabaje con grandes cantidades. Se debe evitar o reducir el uso de material cortante o punzante. Además, se deben seguir unas correctas prácticas de higiene, lavado de manos, uso de guantes y ropa de trabajo, así como una eliminación adecuada de residuos.
Bibliografía
- Félix, M., Tallón, P., Salavert, M. et al. Bacteriemia por Pasteurella spp.: una entidad infrecuente durante los últimos 8 años en nuestro centro. Enferm Infecc Microbiol Clin 2003;21(7):334-9
- Steven J. Schweon, MPH, MSN, RN, CIC, HEM, FSHEA. Infecciones por Pasteurella: una complicación inesperada después de la artroplastia de cadera. Nursing 2016;33(3)
- Wilson BA., Ho M. Pasteurella multocida: from Zoonosis to Cellular Microbiology. Clin Microbiol Rev. 2013; 26(3):631-655. doi:10.1128/CMR.00024-13
- Institut National de Recherche et de Sécurité (INRS). Base de données, EFICATT. Pasteurellose. 2016.
- Institut National de Recherche et de Sécurité (INRS). BAse d'OBservation des Agents Biologiques. Pasteurella multocida subsp. multocida. 2022.
- Institut National de Recherche et de Sécurité (INRS). BAse d'OBservation des Agents Biologiques. Pasteurella spp. 2022.
- Organización Panamericana de la Salud (OPS). Zoonosis y enfermedades transmisibles comunes al hombre y a los animales. Volumen I. Bacteriosis y micosis. 3ª edición. 2001.
- Public Health Agency of Canada. Pathogen Safety Data Sheets and Risk Assessment. Pasteurella spp. 2012.
- Sociedad Española de Enfermedades Infecciosas y Microbiología Clínica (SEIMC). Pasteurella multocida.
- The Center for Food Security and Public Health; Iowa State University Animal disease factsheets. Hemorrhagic Septicemia. 2019.